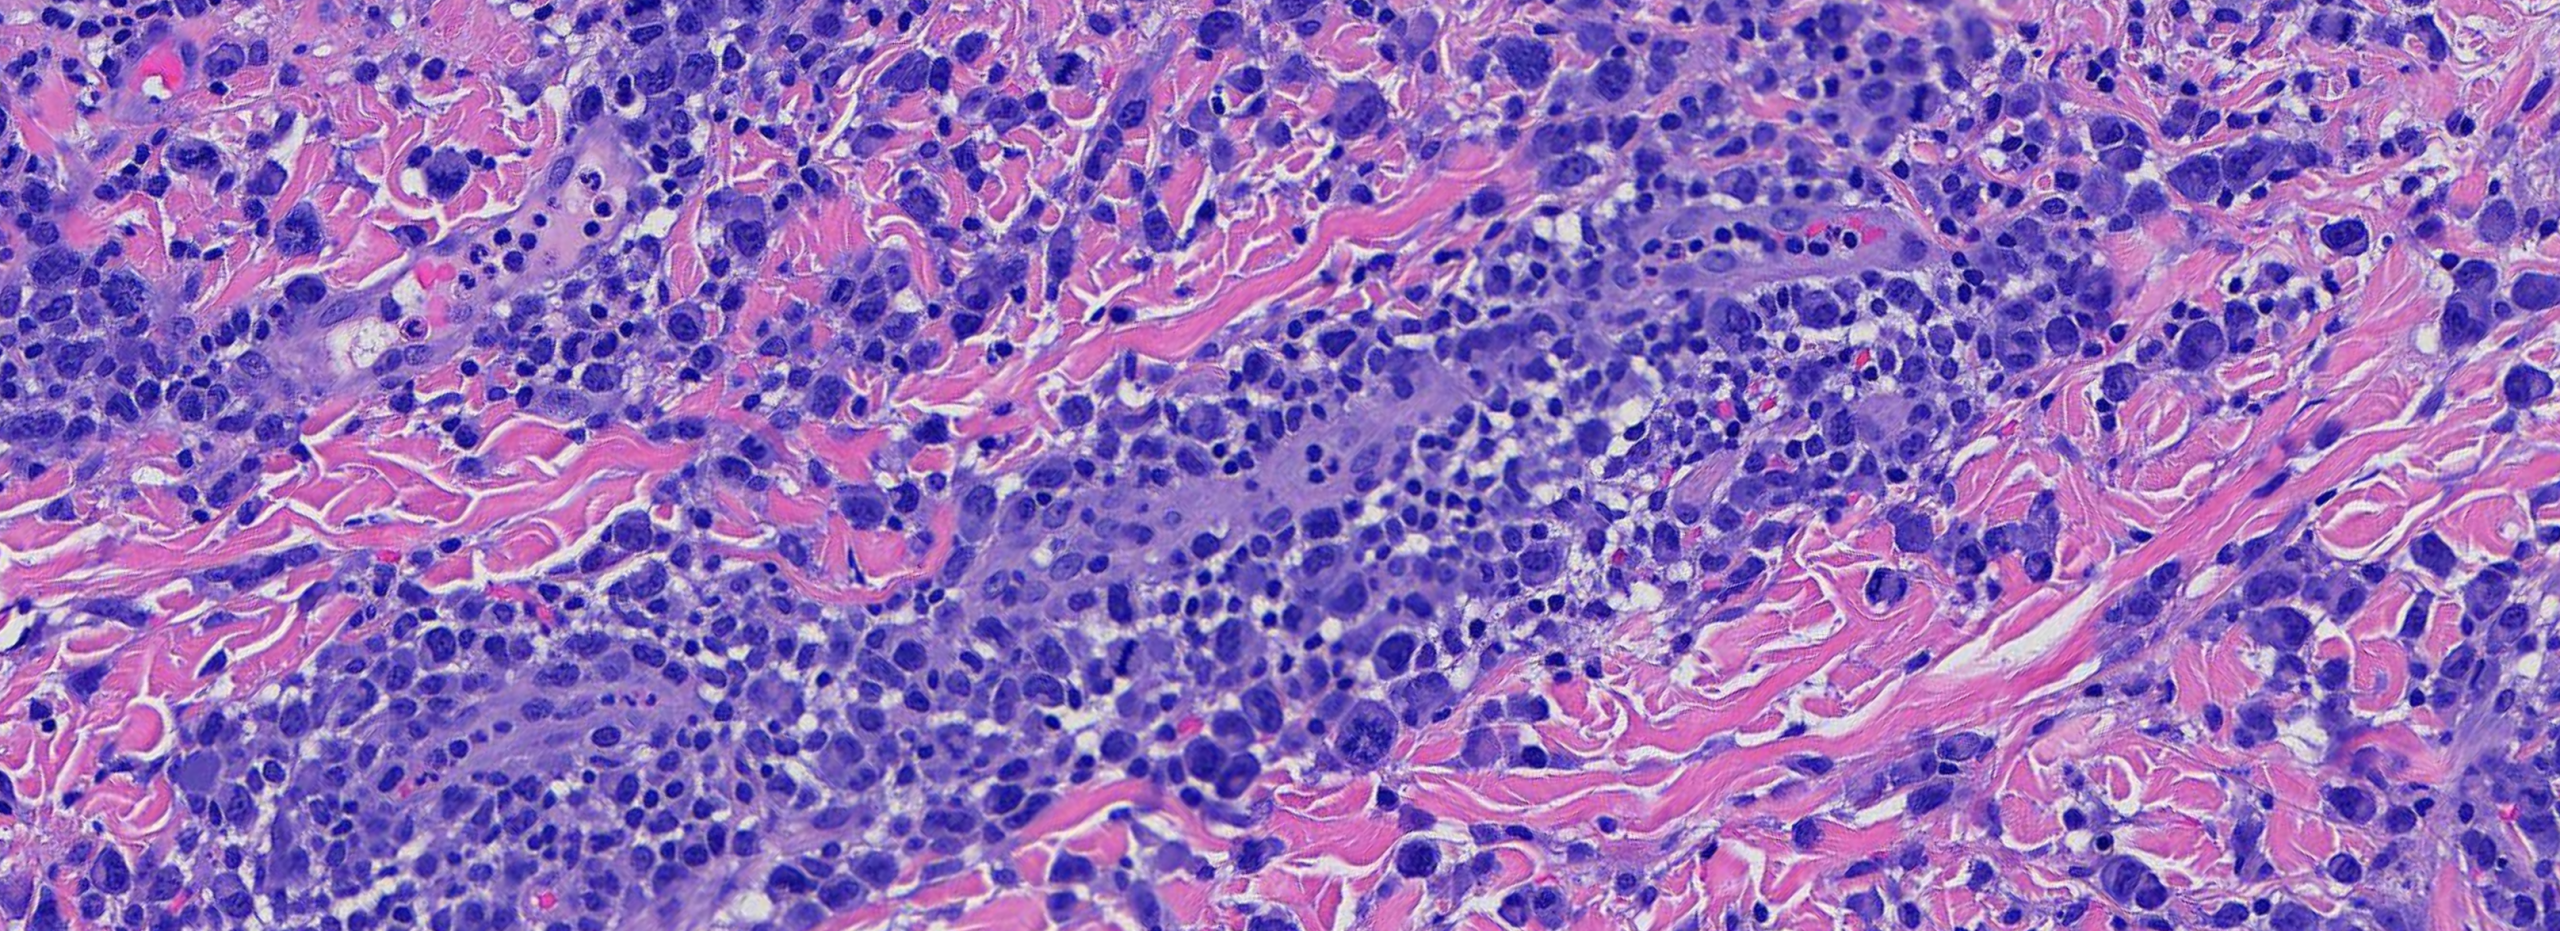
LYMPHOMATOID PAPULOSIS

By Dr. Tom Davis, Sagis Diagnostics
Educational dermpath case series for dermatology residents
Patient: 20-year-old female
Lesion Location: Trunk and extremities
Clinical history: 20-year-old female with a several year history of recurrent crops of self-healing papules and nodules.
A biopsy of a recurrent papulonodular lesion was performed. Take a moment to review the histologic images below — what’s your diagnosis?

(Image 1: Low-power histologic view of papulonodular lesion)
On examination, several defining features stand out:

(Image 2: Medium power showing perivascular and interstitial infiltrate of mononuclear cells)

(Image 3 & 4: High power showing large, atypical mononuclear cells with pleomorphic nuclei.)

(Image 5: Immunohistochemical stain demonstrating CD30 expression of atypical mononuclear cells)
When evaluating a recurrent papulonodular eruption with atypical lymphoid infiltrate like this, several differentials come to mind. Let’s walk through the three most likely contenders and highlight what sets them apart.
Etiology: Idiopathic; believed to represent a clonal T-cell disorder or hypersensitivity reaction, possibly triggered by infection
Histology:
Key Distinction: PLEVA may bear striking histologic similarity to LyP at low power, sharing a superficial and deep lymphocytic infiltrate and necrotic keratinocytes. However, PLEVA lacks the large atypical CD30+ mononuclear cells that characterize LyP. Careful high-power evaluation is essential for this distinction.

(Image 6: PLEVA histology — interface dermatitis without atypical mononuclear cells)
Etiology: Arthropod hypersensitivity — IgE- and cell-mediated immune response to salivary antigens
Histology:
Key Distinction: Insect bite reactions can mimic LyP at low power due to a brisk mixed perivascular infiltrate. The key distinguishing feature is the presence of numerous eosinophils and the conspicuous absence of large atypical CD30+ mononuclear cells. Clinically, insect bites are episodic and site-specific, lacking the chronic waxing-and-waning pattern of LyP.
Etiology: CD30+ T-cell lymphoproliferative disorder; shares a disease spectrum with LyP
Histology:
Key Distinction: PC-ALCL is the most diagnostically challenging mimicker of LyP because both conditions are CD30+ lymphoproliferative disorders existing on the same disease spectrum. Histologically, PC-ALCL shows diffuse cohesive sheets of large CD30+ cells comprising more than 75% of the infiltrate, whereas in LyP the atypical cells are scattered within a rich inflammatory background. The most critical distinguishing feature is clinical: PC-ALCL presents with persistent solitary or localized nodules, while LyP manifests as chronic, recurrent papulonodular lesions that spontaneously resolve.
The combination of large atypical CD30+ mononuclear cells with pleomorphic hyperchromatic nuclei, set within a mixed inflammatory perivascular infiltrate, coupled with a clinical history of recurrent self-healing papulonodular lesions that wax and wane over months to years, is diagnostic of Lymphomatoid Papulosis. Critically, this diagnosis cannot be made on pathology alone — clinicopathologic correlation is paramount.
Key Takeaways for Residents:
| Feature | LyP | PLEVA | Insect Bite Reaction | PC-ALCL |
| CD30+ cells | ✅ Present | ❌ Absent | ❌ Absent | ✅ Present (>75%) |
| Atypical mononuclear cells | ✅ Scattered | ❌ Absent | ❌ Absent | ✅ Diffuse sheets |
| Eosinophils | ❌ Absent | ❌ Absent/rare | ✅ Numerous | ❌ Absent |
| Spontaneous resolution | ✅ Yes | ✅ Yes | ✅ Yes | ❌ No |
| Recurrent crops | ✅ Yes | ✅ Yes | ❌ No | ❌ No |
| Lymphoma risk | ✅ 4–25% | ❌ None | ❌ None | ✅ Malignant |
| Behavior | Benign (chronic) | Benign | Benign | Locally aggressive |
The CD30+ lymphoproliferative disorders exist on a spectrum with considerable microscopic and immunohistochemical overlap. Definitive and correct diagnosis is only possible when the microscopic findings are correlated with patient history and clinical findings.
Sagis Diagnostics is proud to support dermatology residents and dermatology residency programs through high-quality educational content and histopathologic learning resources. Follow us on Instagram for more micro-learning opportunities with interactive cases and pathology insights.
Are you interested in viewing other dermpath diagnostic videos like this?
Type a diagnosis in the search window below to see applicable videos.
Related Case Reviews
Join Our Dermpath Educational Community
Access expert-led content, and stay in the loop on upcoming sessions and resources from our Dermpath Educational community.
There are no specimen slides available for this interview session. Enjoy the session!
Did you know we are a diagnostic lab?
Sagis Dermatopathology delivers accurate, timely diagnoses with dedicated support from our lab team and direct access to our dermatopathologists.
CAREER RESOURCES
Looking for a Job after Graduation?
Click: https://www.sagisdx.com/post-residency-fellowship/
Let us know what you’re looking to specialize in. We’ll help connect you to our wide network.